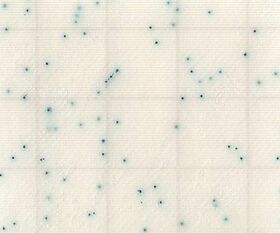

説明
【特徴】
●手軽にかつ正確な微生物検査が可能です。
●サンプルを培地パッドに滴下するだけですので、不慣れな方でも取り扱いが容易です。
●経験の差が出にくくなります。
●発育した菌は特徴的な発色コロニーを形成しますので、判定が容易です。
●運動性の高い菌も計測しやすく、判定に経験の差が出にくくなっています。
●滅菌された出来合い培地ですので、培地調製が不要です。
●食材等の試料液検査をはじめスタンプ法・塗抹法・メンブランフィルター法・落下菌の検査が可能です。
●かさばらず、長期保存が可能です。
●省スペース化と廃棄量低減により、環境にやさしい製品です。
●国際認証 MicroVal、AOAC PTM 認証取得
●食品衛生検査指針収載
【仕様】
●対象菌:黄色ブドウ球菌
●入数:1箱(25枚/袋×4袋入)
●培養条件:35℃ 24時間
●保存方法:2-15℃の冷蔵庫
●アルミ袋開封後、未使用のシート培地はアルミ袋にシールして冷蔵保管。
●★MicroVal認証No.:2015LR56
●★AOAC PTM認証No.:051704
追加情報
メーカー名:
JNC
メーカー品番:
SK03B25
予定納期:
注文から1~3日で発送